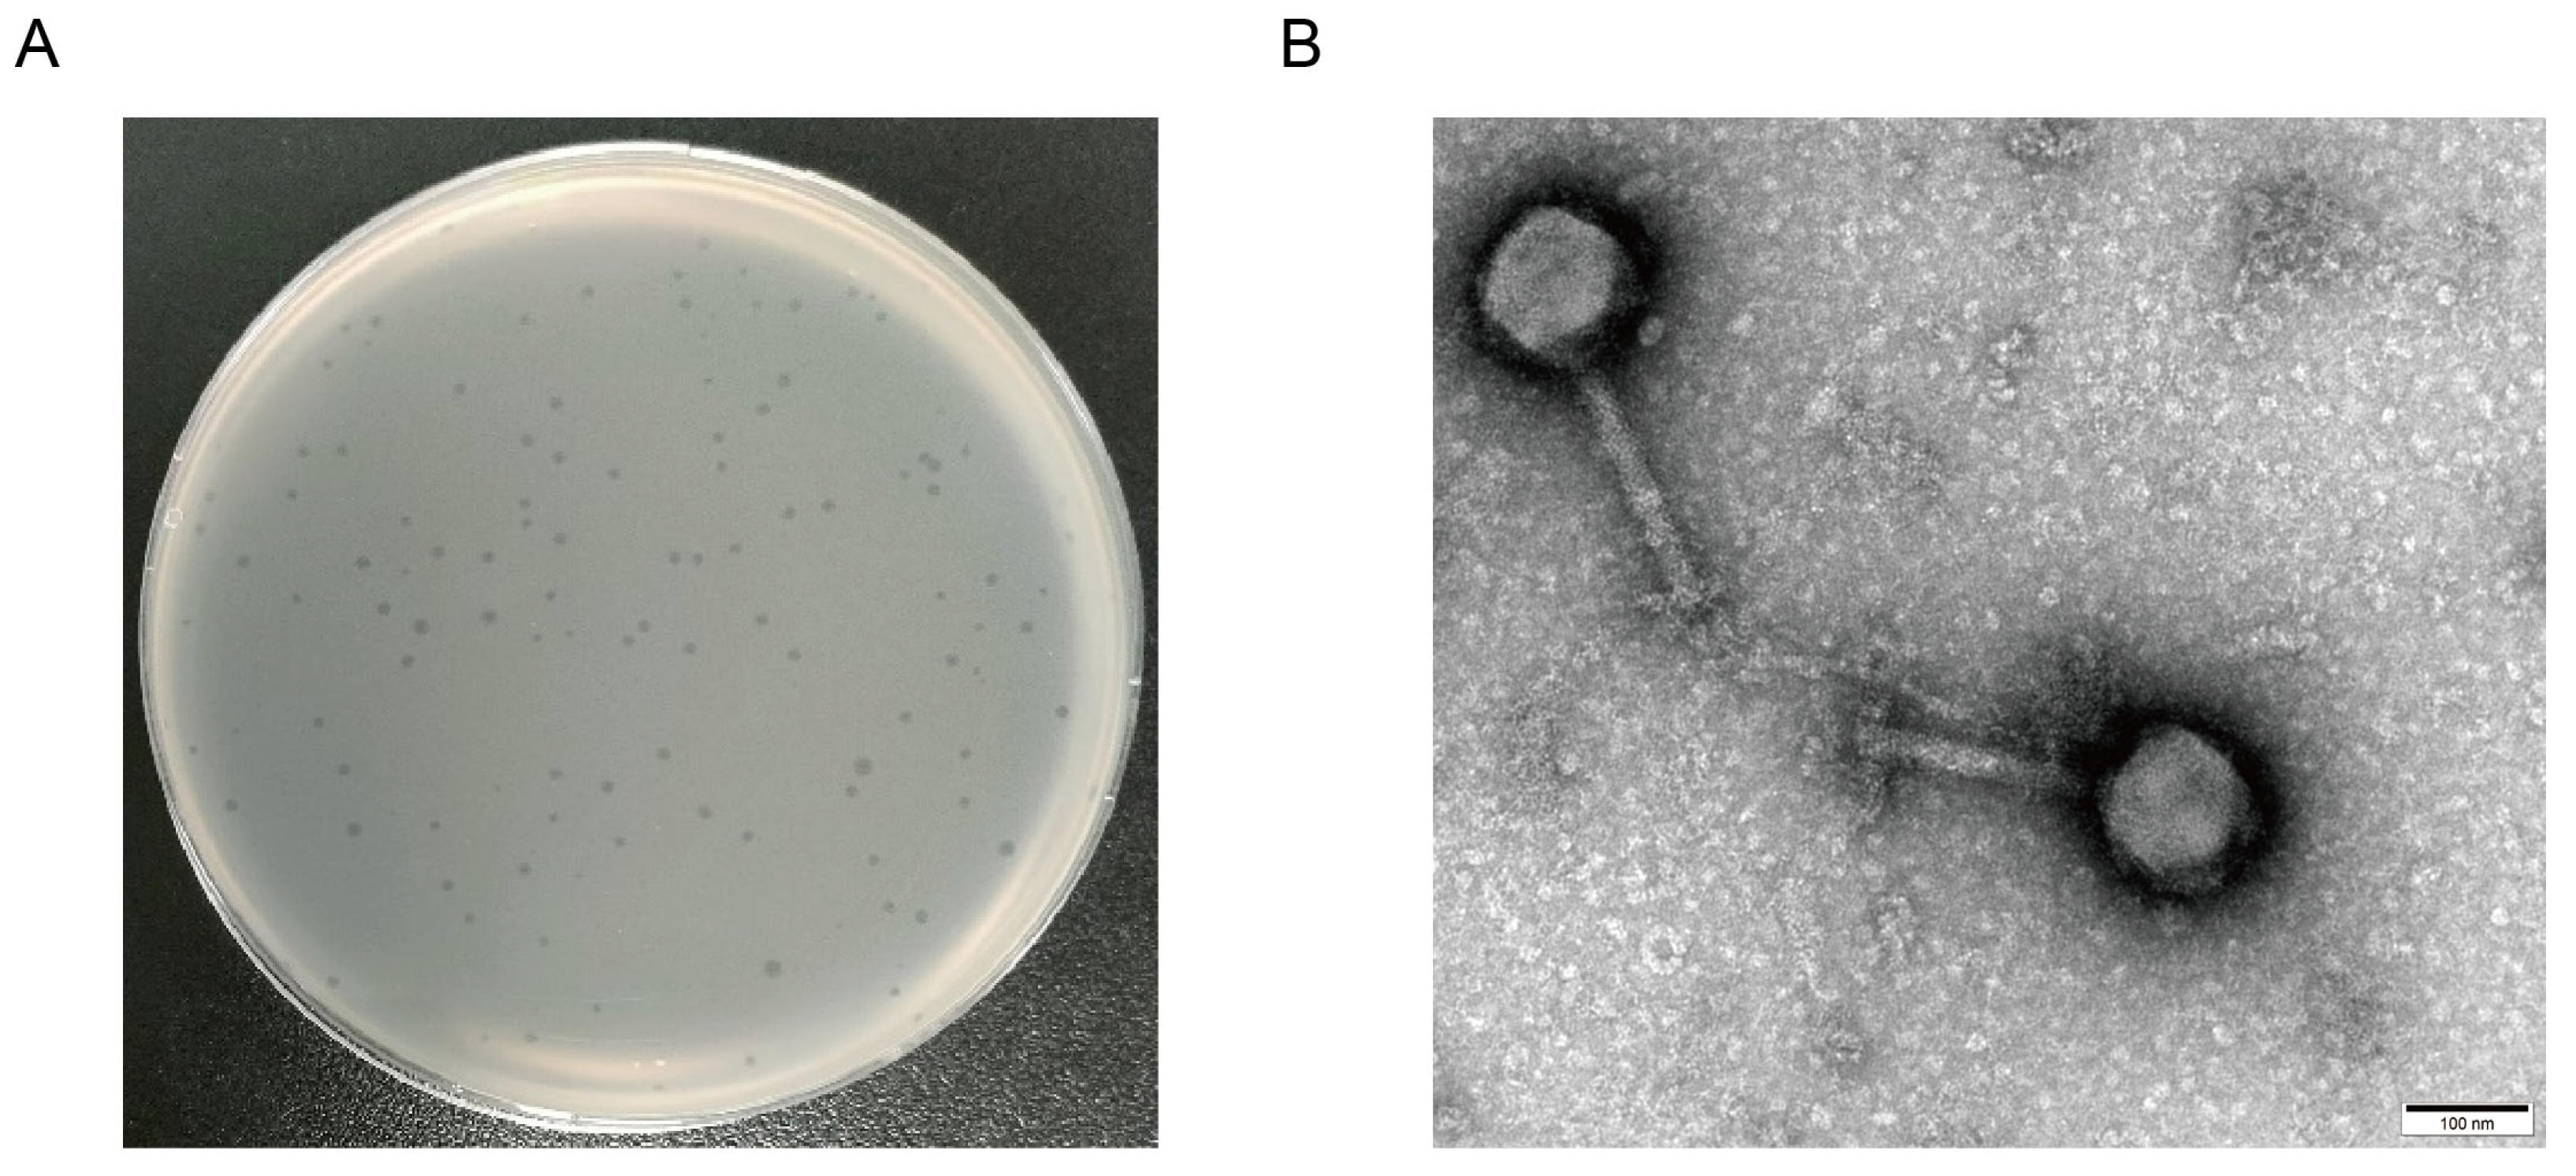
Microorganisms 12 02400 g001

Abstract
Salmonella, a prevalent foodborne pathogen, poses a significant social and economic strain on both food safety and public health. The application of phages in the control of foodborne pathogens represents an emerging research area. In this study, Salmonella pullorum phage vB_SpuM_X5 (phage X5) was isolated from chicken farm sewage samples. The results revealed that phage X5 is a novel Myoviridae phage. Phage X5 has adequate temperature tolerance (28 °C–60 °C), pH stability (4–12), and a broad host range of Salmonella bacteria (87.50% of tested strains). The addition of phage X5 (MOI of 100 and 1000) to milk inoculated with Salmonella reduced the number of Salmonella by 0.72 to 0.93 log10 CFU/mL and 0.66 to 1.06 log10 CFU/mL at 4 °C and 25 °C, respectively. The addition of phage X5 (MOI of 100 and 1000) to chicken breast inoculated with Salmonella reduced bacterial numbers by 1.13 to 2.42 log10 CFU/mL and 0.81 to 1.25 log10 CFU/mL at 4 °C and 25 °C, respectively. Phage X5 has bactericidal activity against Salmonella and can be used as a potential biological bacteriostatic agent to remove mature biofilms of Salmonella or for the prevention and control of Salmonella.
1. Introduction
Salmonella is a common foodborne pathogen that poses a risk to public safety [1]. It is a zoonotic pathogen that causes foodborne outbreaks and epidemics of varying degrees worldwide [2,3]. Salmonella is responsible for 80% to 90% of food-borne bacterial poisonings in China [4]. In Columbia and Puerto Rico, a total of 1135 individuals became ill due to consuming poultry contaminated with Salmonella in the 2021. Among them, 2 people died and 273 were hospitalized [5]. Salmonella pullorum is highly infectious in chicks under three weeks of age, with morbidity and mortality rates reaching up to 100%. This pathogen significantly impacts the performance and intestinal health of poultry, leading to severe economic losses for the poultry industry [6,7]. Currently, the best strategy to reduce pullorosis is to eliminate S. pullorum in chicken farms [8]. Chickens infected with Salmonella represent the main source of Salmonella infection in humans [9]. Salmonella usually contaminates a variety of foods such as milk, eggs, and meat.
Phages or bacteriophages are viruses that invade bacteria. Phages, which are avirulent, specific, and sensitive to drug-resistant bacteria [10,11], have been seldomly studied as a bacteriostatic agent to prevent pathogens from contaminating foods and to ensure food safety [12,13]. The phage mixture provides reference for the research and application of phages against Salmonella infection in chicken [14]. Bacteria in biofilms are not affected by antibiotics. As a result, they are difficult to treat. Few studies have demonstrated the effectiveness of phages and their derivatives in inhibiting S. typhimurium biofilms [15]. However, there is limited information on the application of phages to remove mature biofilms of S. pullorum and reduce S. pullorum contamination in chicken breasts in China. To the best of our knowledge, this is the first study that evaluates the effect of phages on the biofilm of S. pullorum, providing some reference for the control of the bacteria.
In this study, Salmonella phage X5 was isolated from sewage samples obtained from a chicken farm. The morphological and biological characteristics of the phage were determined, and the effect of the phage on the biofilm formation of Salmonella was evaluated. In addition, the bacteriostatic activity of the phage in milk and chicken breast meat was studied, which provided a theoretical basis for the development of bacteriostatic agents in foods.
2. Materials and Methods
2.1. Bacterial Strains and Media
S. pullorum 519 (CVCC 519) was purchased from the China Veterinary Culture Collection Center (CVCC, Beijing, China). The study used seven different strains of tested bacteria, including 80 Salmonella strains containing 3 different serotypes and 4 non-Salmonella strains (Table 1). These strains were stored at the Laboratory of Animal Pathology, College of Veterinary Medicine, Huazhong Agricultural University. Luria–Bertani (LB) broth and LB nutrient agar medium (Qingdao Haibo Biotechnology Company, Qingdao, China) were used for bacterial culture.

Table 1.
Lytic activity of phage X5 against the tested strains.
2.2. Isolation, Identification and Purification of Phage X5
Chicken feces and sewage samples were collected from a large-scale chicken farm in Hubei Province. Phage isolation was performed as previously described [16]. Briefly, all samples were centrifuged at 11,000× g for 15 min to remove large particulate matter and were then passed through a 0.22-μm filter (Millipore, Burlington, MA, USA) to remove bacterial cells and small impurities. Phage enrichment was achieved by mixing 0.1 mL of S. pullorum 519 solution with 1 mL of filtrate and 10 mL of LB broth. The mixture was cultured overnight in a 37 °C incubator, centrifuged at 11,000× g for 15 min, and passed through a 0.22-μm filter. The traditional double-layer agar (DLA) technique was used to verify the presence of phages [17]. DLA plates were incubated overnight at 37 °C. Positive samples were those with transparent plaques. Clear plaques were selected and purified five times to obtain purified phages. The phages were stored at 4 °C prior to use and stored at −80 °C with 30% glycerol for long-term storage.
2.3. Determination of Host Range of Phage X5
The host range of phage X5 was determined using the dropping method [18]. Except for Clostridium perfringens and Lactobacillus acidophilus, the transparent lawns of the tested strains were formulated with LB nutrient agar. The lawns of C. perfringens were prepared using TSC medium supplemented with 0.05% D-cycloserine, and those of L. acidophilus were prepared using MRS medium with 1.5% agar based on 42 °C. A phage suspension of 5 μL (108 PFU/mL) was dropped on the lawns of the strain. The plates were incubated overnight at 37 °C to form transparent lytic plaques. Plaque formation confirms the host’s susceptibility to phages. The phage host range of each test strain was assessed using a scoring system [19]. The experiment was repeated three times.
2.4. Determination of Biological Characteristics of Phage X5
Phage X5 was incubated under different conditions to determine its tolerance to various environments. The purified phage samples (1 mL phage, 1010 PFU/mL) were incubated at 28, 37, 50, 60, and 70 °C to determine the thermal stability, and the titers were determined by the DLA method at 20, 40, and 60 min [20]. To assess pH tolerance, 100 μL phage suspension (1010 PFU/mL) was mixed with 900 μL fresh LB broth at different pH values (pH 2–12, adjusted with HCl or NaOH). After oscillating the phage suspensions at 37 °C for 1 h (160 rpm/min), the phage titer was determined using the DLA technique [21,22].
According to the infection ratio of 1000, 100, 10, 1, 0.1, 0.01, and 0.001, the mixture of Salmonella CVCC519 and phage X5 was supplemented with LB broth, so that the final volume of each tube was the same. Each treatment had three replicates. The phage titer was determined by the DLA method in a shaker (150 rpm) at 37 °C for 4 h [23]. Chloroform was mixed with phage X5 at 0, 25, and 50% [24]. Each mixture was incubated at 220 rpm for 1 h at 37 °C. Phage titer was determined by the DLA technique. The experiments were carried out in triplicate.
2.5. Adsorption Rate Determination
In this experiment, 3 mL of the logarithmic growth stage of S. pullorum (CVCC 519) was transferred into a centrifuge tube. Subsequently, phage X5 (3 mL) was added according to the optimal multiplicity of infection (MOI; 0.01). The mixture was placed on a shaking table at 37 °C (150 rpm/min) and incubated for 50 min. We then removed 200 μL of the mixture every 5 min and placed it on ice for 1 min. The mixture was centrifuged at 12,000 rpm/min for 1 min, and the phage titer in the supernatant was determined using the DLA technique. The experiment was repeated three times. The phage adsorption rate was calculated using the following formula:
Phage adsorption rate = [(total number of initial phages − number of unadsorbed phages)/total number of initial phages] × 100% [25].
2.6. One–Step Growth Curve of Phage X5
One–step growth curve tests were performed as previously reported [26]. The phage lysate with a MOI of 0.01 and its host bacteria were added to LB broth medium and incubated at 37 °C for 10 min. The mixed medium was centrifuged at 12,000 rpm for 8 min, the supernatant was discarded, and the precipitate was washed three times with LB broth medium. Subsequently, 10 mL of preheated LB liquid medium at 37 °C was added to the precipitate and thoroughly mixed. The culture was mixed by oscillation at 160 rpm at 37 °C. Samples (100 μL) were collected every 10 min for 120 min and diluted in LB broth to determine the phage titer. The filtrate titer was determined by the DLA technique. The latency period is defined as the shortest time required for the phage to adsorb to the host bacteria and release progeny phages. The phage burst size represents the late phage burst titer divided by the concentration of host bacteria at the initial infection stage [27]. The experiment was repeated three times.
2.7. Transmission Electron Microscopy (TEM) of Phage X5
Freshly prepared phages (1010 PFU/mL) were centrifuged at 45,000× g for 2 h at 4 °C and precipitated with 500 μL of 0.1 M ammonium acetate. The phage drops were placed on a mesh for 10 min and stained with 2% (w/v) phosphotungstic acid for 15 min. The stained phages were photographed by TEM (Hitachi H–7000FA, Tokyo, Japan) at 75 kV [28]. The head diameter and tail length of phage X5 were measured using Digital Micrograph Demo 3.9.1 (Gatan, Inc., Pleasanton, CA, USA).
2.8. Phage X5 DNA Extraction and Genome Sequence Analysis
The extraction of phage X5 genomic DNA was performed as previously reported [29] and sequenced in an Illumina HiSeq platform (Illumina Inc., San Diego, CA, USA) [30]. Assembly of the reads was performed using SPAdes (version 3.12.0) software [31].
GeneMarkS (http://exon.gatech.edu/GeneMark/, accessed on 5 May 2024) and RAST (https://rast.nmpdr.org/rast.cgi, accessed on 5 May 2024) were used to predict the genome sequence of phage X5. The phage X5 genome map was generated by CGviewServer (http://cgview.ca/ accessed on 7 May 2024) [32]. The comprehensive antibiotic resistance database (CARD, http://arpcard.mcmaster.ca, accessed on 10 May 2024) and virulence factor database (VFDB, http://www.mgc.ac.cn/VFs/, accessed on 10 May 2024) were used to screen antibiotic resistance and virulence factor–related genes, respectively. A visual genome map of phage X5 was generated using an online website (https://cgview.ca/, accessed on 15 May 2024). The BLASTn webline website (https://blast.ncbi.nlm.nih.gov/Blast.cgi, accessed on 20 May 2024) was used to compare the nucleotide sequences of phages and search for highly similar phages in GenBank. BLASTP was used to search the NR (Non–Redundant) protein database and identify the functional annotation of CDS (Coding sequence) [33,34]. The functions of open reading frames (ORFs) were annotated using BLASTP and the Rast database. Using the virus classification of the International Committee on Taxonomy of Viruses and BLASTn of NCBI database (https://blast.ncbi.nlm.nih.gov/Blast.cgi, accessed on 20 May 2024), their terminal enzyme large subunits were selected to show significant similarity. MEGA 10 was used for phylogenetic and evolutionary analyses [35]. Visual genome comparison of phage X5 and GSP044 was performed using Mauve 2.3.1 [36]. The whole genome sequence of phage X5 has been uploaded to NCBI database (GenBank number: PP502935).
2.9. Ability of Phage X5 to Reduce Salmonella Biofilm Formation
To evaluate the impact of phage X5 on biofilm formation, this study referred to previous research and made slight modifications to the methodology [37,38,39]. First, the concentration of fresh CVCC519 was adjusted to OD600 = 0.5 (about 1 × 109 CFU/mL). Second, 1 mL bacterial solution was added to each well of the 24–well cell culture plate, followed by 1 mL LB medium. Third, following three days of incubation at 37 °C, the medium was discarded, the wells were washed with 1 mL sterile phosphate buffered saline (PBS) three times, and phage X5 (105 PFU and 107 PFU) was added. Fourth, after incubation at 37 °C for 6 h, the media were discarded and washed three times with sterile PBS. Fifth, the bacterial load in the biofilm was measured. For the biofilm determination assay, following the addition of 1 mL of 95% methanol per well and incubation for 30 min, the fixed solution was discarded, and each well was washed three times with PBS. Subsequently, 1 mL crystal violet solution (1%) was added, and the plate was incubated for 30 min at room temperature. After washing with PBS three times, 1 mL of anhydrous ethanol was added for decolorization. Absorbance was measured at OD600. The bacteria were incubated, and the phage was replaced with an equal amount of SM buffer (Tris/NaCl/MgSO4), stained with crystal violet, and decolorized with ethanol. Absorbance was measured at OD600. Three parallel samples were set up for each experiment, and the experiments were repeated three times.
2.10. Inhibitory Effect of Phage X5 on Salmonella in Foods
The effects of the phage on Salmonella in different food substrates were evaluated in raw chicken breast and milk from a supermarket in Wuhan City.
Milk was confirmed to be aseptic by plate coating. Milk (9.8 mL) was mixed with 100 μL phage X5 (108 or 109 PFU/mL) and inoculated with 100 μL S. pullorum 519 (106 CFU/mL, PBS suspension). The control groups consisted of 200 μL PBS. The mixtures were incubated at 25 °C and 4 °C. Samples were collected at 0, 2, 4, 6, 8, 18, and 24 h, and the recoverable bacteria in milk were detected by the Salmonella Shigella (SS) Agar plate counting method [40,41].
The raw chicken breasts were divided into small pieces (2 × 2 cm), placed on a clean workbench, and irradiated by UV for 20 min to ensure disinfection and sterilization. then, 100 μL log–growth Salmonella CVCC 519 (106 CFU/mL) was added to each experimental sample and incubated at room temperature for 15 min. Subsequently, 100 μL of the phage (108 PFU/mL, MOI = 100 and 109 PFU/mL, MOI = 1000) was added, while an equal amount of sterile saline was added as a negative control. The treated samples were incubated at 4 °C for 0, 2, 4, 8, 18, and 24 h. Each piece of chicken was cut with sterile scissors and added to 1 mL sterile normal saline and mixed by oscillation for 3 min. The amount of Salmonella on the chicken pieces was determined by the dilution coated plate counting method [16].
2.11. Statistical Analysis
Data were statistically analyzed using GraphPad Prism 8.0.1 (San Diego, CA, USA). Results are presented as mean ± standard deviation (SD), and significance analysis between groups was performed using one–way ANOVA. Statistical significance was set at p < 0.05.
3. Results
3.1. Isolation and Identification of Salmonella Phage
A strain of Salmonella phage was isolated from the sewage samples of a chicken farm. The morphology and size of the plaque were similar (Figure 1A). The plaque, which was transparent and had no halo, was labeled vB_SpuM_X5 (X5). Phage X5 had a typical icosahedral structure with a head diameter of about 130 nm, a tail diameter of about 210 nm, and a retractable tail, consistent with the characteristics of Myoviridae (Figure 1B).

Figure 1.
Morphology and microscopic morphology of phage X5 plaque. (A) Phage X5 plaque morphology. (B) Microscopic morphology of phage X5 under transmission electron microscopy. The scale is 100 nm.
3.2. Host Range of Phage X5
Three serotypes of Salmonella were used to test the host range of phage X5. Host range analysis showed that phage X5 could form a transparent phagocytic circle when co–cultured with 70 strains of Salmonella. The cleavage rate reached 87.50% (70/80). However, phage X5 could not infect other genera of bacteria (Table 1). Additionally, phage X5 could not infect all the Gram–negative bacteria tested (Klebsiella pneumoniae and Escherichia coli) or two of the Gram–positive strains (Lactobacillus acidophilus and Clostridium perfringens).
3.3. Biological Characteristics of Phage X5
Figure 2 shows the biological characteristics of phage X5. The initial titer of phage X5 was 1010 PFU/mL. The titer of phage X5 was stable at 28 °C and 37 °C (Figure 2A). When the temperature was raised from 50 °C to 60 °C, the titer of the phage decreased and subsequently stabilized. The titers dropped sharply from 0 to 20 min, and the rate of the decline decreased from 20 to 60 min, whereas the phages were completely inactivated after 20 min at 70 °C. Figure 2B shows that phage X5 remained active and stable at pH 4–12; however, its stability decreased sharply and its titer could not detected at pH 2. Figure 2C shows the optimum MOI of phage X5. Phage X5 had the highest titer at MOI = 0.01; hence, the optimal MOI of phage X5 was 0.01, indicating that a small quantity of phages has the potential to lyse a significant number of bacteria, resulting in optimal titers.

Figure 2.
Biological characteristics of phage X5. Stability of phage X5 at different temperatures (A) and pH values (B). (C) Optimal MOI of phage X5. (D) Determination of chloroform sensitivity of phage X5. (E) Adsorption rate of phage X5. (F) One–step growth curve.
Figure 2D shows the results of the chloroform sensitivity test. At ≤25% chloroform, the phage X5 titer was stable and high. At 50% chloroform, phage X5 was significantly reduced, but not completely inactivated.
3.4. Adsorption Rate
The adsorption rate of phage X5 increased from 0 to 20 min and reached its peak at 20 min with an adsorption rate of 81.0%. After 20 min, the adsorption rate began to decline (Figure 2E).
3.5. One–Step Growth Curve
Figure 2F shows a one–step growth curve of phage X5 at MOI = 0.01. The latent period was 10 min, the lysis period was 10–70 min, and the number of phages increased rapidly. In addition, the mean burst size of phage X5 was estimated to be 120 PFU/cell.
3.6. Whole–Genome Sequencing and Coding Gene Prediction of Phage X5
The genome sequencing results for phage X5 are shown in Figure 3. The genome consists of 118,240 bp of double–stranded DNA with a GC content of 39.40%. The protein sequences of all genes were compared with those in CARD and VFDB database. No pathogenic factors, resistance genes, genes related to phage lysogenicity, or virulence genes were found, indicating their safety. BLAST–N analysis showed that the X5 genome had the highest homology with Salmonella phage S124 (GenBank: OK108607) of the Myoviridae family, with 98.51% homology.

Figure 3.
Genome map of phage X5 generated by CGView. Green areas indicate the distribution of the coding sequence (CDS) regions; arrows indicate the direction of transcription. The total GC.
Figure 4 shows the multi–genome alignment and phylogenetic tree analysis of phage X5 and Salmonella phage S124, ABTNLsp, E22, SSP1, SE8, SE11, GSP044, Th1, and L6jm.

Figure 4.
Phylogenetic evolutionary tree of phage X5. The phylogenetic tree was constructed based on the neighbor–joining method of the terminase large subunit.
GSP044 and X5 with the highest similarity were selected for genomic collinearity analysis. Some genes were in different regions, indicating that phage X5 may exhibit gene rearrangement (Figure 5). Similar color blocks represent putative homologous blocks. The height of the internal lines in the block represents the conservatism of the average sequence in the region, and the higher the height, the better the conservatism. The white area inside the block represents a region where homologous blocks cannot be found in other genomes. The top and bottom of the block represent the justice chain and the antisense chain. Red usually indicates a mismatch between two genomes, and green indicates a match. Phage GSP044 (GenBank: OP394141) was isolated from Huizhou City, Guangdong Province, China.

Figure 5.
Collinearity analysis of phage X5 and GSP044 genomes.
Table 2 shows the protein analysis of phage X5. The phage genome consists of several gene cluster modules: DNA replication; repair and modification enzymes such as DNA helicase (ORF124), DNA replication primase (ORF121), and DNA polymerase (ORF122); DNA packaging proteins such as terminase small subunit (ORF95), portal protein (ORF150), and terminase large subunit (ORF152); lysis compounds such as lysozyme (ORF41) and holin (ORF42); and structural proteins such as tail fiber protein (ORF142), baseplate protein (ORF117), capsid protein (ORF147), and scaffold protein (ORF101). ORF100 encodes the phage principal protein. ORF99 encodes HNH endonuclease, an intron protein with sequence tolerance and site specificity. Thymidylate synthase (ORF93) is involved in nucleotide metabolism. The X5 genome encodes some additional proteins, such as serine/threonine phosphatase (ORF36) for amino acid biosynthesis. ATP-dependent helicase (ORF124) is involved in fundamental biological processes such as transcription, proliferation, and repair of DNA. ORF143 encodes the major tail protein of phage, while ORF142 encodes the tail fiber of phage. The phylogenetic tree of X5 was constructed based on the nucleotide sequence of the terminase large subunit (ORF152). The location and homology of the major ORFs in phage X5 and GSP044 are shown in Table 2. It is worth noting that the X5’s ORF99 does not exist in GSP044, which is thought to be a gene insertion.

Table 2.
Functional analysis of major proteins of phage X5.
No phage transposase, toxins, excision enzyme homology, virulence factors, or repressors were predicted in the X5 genome. According to the sequencing results, phage X5 is a novel phage.
3.7. Scavenging Effect of Phage X5 on Bacterial Biofilm
To evaluate whether phage X5 can destroy the biofilm formed by S. pullorum 519, the biofilm treated with phage X5 was stained using the CV method. Phage X5 significantly removed the biofilm, even at low concentrations (105 PFU/mL; Figure 6A,B (p < 0.001). Compared with the control group, the phage–treatment group had a significantly lower bacterial load (Figure 6C) (p < 0.001). This finding suggests that phage X5 can effectively reduce the biofilm formed by S. pullorum 519. Phage X5 effectively reduced the number of bacteria in the biofilm (Figure 6D).

Figure 6.
Effect of phage X5 on bacterial biofilm. The initial titers of phage X5 were 105 and 107 PFU/well. The biofilm biomass was obtained after incubation for 24 h. (A) Crystal violet staining analysis. (B) Optical density values measured at 600 nm. (C) Plate count results. The results are expressed as the mean ± SD (standard deviation) of three independent experiments. The one–way ANOVA method was used to assess significant differences between control and test samples. *** p < 0.001, **** p < 0.0001. (D) Pattern diagram of phage entry into bacteria.
3.8. Inactivation of Salmonella in Different Food Models by Phage X5
The bactericidal power of phage X5 was evaluated in solid foods (raw chicken) and liquid foods (milk).
3.8.1. Bacteriostasis of Phages in Milk
The inhibitory effect of phage X5 on Salmonella in milk is shown in Figure 7A.

Figure 7.
Application of phage X5 in the biological control of S. pullorum 519 in milk. (A) Effects of phage X5 on the growth of S. pullorum 519 in milk at 4 °C. (B) Effects of phage X5 on the growth of S. pullorum 519 in milk at 25 °C. * p < 0.05; ** p < 0.01; *** p < 0.001.
Phage X5 at MOI of 100 and 1000 reduced live Salmonella counts (S. pullorum) compared with untreated controls. At 4 °C, the number of bacteria in the control group did not increase with time and remained at about 4 log10 CFU/mL. Following incubation at 4 °C for 24 h, compared to the control group, the number of viable bacteria in the MOI = 100 and MOI = 1000 groups were reduced by 0.72 log10 CFU/mL (p < 0.01) and 0.93 log10 CFU/mL (p < 0.001), respectively (Figure 6A). The maximum antibacterial efficiency was 80.70 and 88.10%, respectively.
At 25 °C, the inhibitory effect of phage X5 on Salmonella in milk was similar to that at 4 °C. The number of Salmonella in the control group increased significantly with prolonged time within 24 h, from 4.21 log10 CFU/mL to 8.23 log10 CFU/mL (Figure 7B). Salmonella counts were reduced by 0.66 log10 CFU/mL (p < 0.01) and 1.06 log10 CFU/mL (p < 0.001) with MOI of 100 and 1000, respectively. The inhibitory effect was greater at MOI = 1000 than at MOI = 100.
3.8.2. Bacteriostasis of Phages in Chicken Breast
The inhibitory effect of phage X5 on host bacteria on chicken surface is shown in Figure 8. At 4 °C, at 2–24 h phage treatment with an MOI of 100, the Salmonella count on chicken breast meat decreased from 4.6 log10 CFU/mL to 3.47 log10 CFU/mL (p < 0.01; Figure 8A). After treatment with a MOI of 1000 for 2–24 h, the Salmonella count on chicken breast decreased from 4.6 log10 CFU/mL to 2.18 log10 CFU/mL (p < 0.001) (Figure 8B). At 25 °C, the total number of Salmonella bacteria in each group gradually increased with time. At 2 h, the number of Salmonella counts was significantly lower in the phage–treated groups (MOI = 100 and 1000) than in the control group. At 24 h, the total amount of Salmonella bacteria in the phage–treated groups decreased by 0.81 log10 CFU/mL (MOI = 100) and 1.25 log10 CFU/mL (MOI = 1000) compared with the control group. The results showed that phage X5 had an adequate bacteriostatic effect on the chicken surface. Additionally, the bacteriostatic effect was greater at MOI = 1000 than at MOI = 100.

Figure 8.
Application of phage X5 in biological control of S. pullorum 519 in chicken breast. (A) Effects of phage X5 on the growth of S. pullorum 519 in chicken breast at 4 °C. (B) Effects of phage X5 on the growth of S. pullorum 519 in chicken breast at 25 °C. * p < 0.05; ** p < 0.01; *** p < 0.001.
4. Discussion
Phages can efficiently lysate pathogenic bacteria. The application of phages reduces the need for antibiotics and promotes food safety. Phages have been widely used in clinical medicine, animal husbandry, aquaculture, and agriculture [3,42].
S. pullorum causes pullorum disease, which persists in adult chickens without obvious clinical symptoms and can spread vertically and horizontally, endangering the development of the poultry industry [43,44]. Salmonella phage CKT1 effectively controls the vertical transmission of S. pullorum in adult broilers [45]. Specifically, phage CKT1 significantly reduces weight loss in chickens infected with S. pullorum by regulating the abnormal intestinal flora and can be used as a potential substitute for antibacterial growth promoters in poultry farms [46]. Controlling S. pullorum in chicken farms is an effective strategy to prevent human infection.
The application of phages for the control of bacterial pathogens in foods is an emerging area. The commercial interest in this area has gradually increased since the FDA approved the limited use of phages in fresh foods to control Listeria monocytogenes [47]. Phages have host specificity, which is an important factor limiting the therapeutic efficacy of phages against bacterial infections [48]. Therefore, phages with broad host spectrum have broad application prospects. A broad–spectrum Salmonella phage capable of lysing five Salmonella serotypes has been isolated [49].
As research advances, the issues of phage safety, stability, and the development of bacterial resistance will be resolved, and the screening of novel phages and mixed preparations will become a hot spot in the antibacterial realm [50]. The latency of phage X5 was shorter than those of other phages reported, which may be related to the high lytic activity of phage X5 [51,52]. Phages with short latency can lyse more bacteria in a short period of time; hence, they are suitable for biological control [53,54].
Phage X5 was stable at pH 4–12 and had high pH tolerance. The stability of phage X5 in acidic and alkaline conditions allows it to be used in food with different pH values. Phage X5 had better bacteriostatic effects in milk than in chicken breast, which may be due to the adsorption of phage to bacteria in a liquid food matrix as result of the fluidity of milk [55]. Phage X5 has a binary lysis system composed of holin and lysozyme, which destroy the cell membrane and cell wall of bacteria, respectively, and has a completely different mechanism of action from antibiotics [56,57]. The tail fiber protein is responsible for the specific initial recognition of host bacteria and can be a potential biological cognitive element for detecting bacteria [58,59]. The application of phages and their derivatives, such as endolysin, as biological control agents has been documented [60].
In the study, the genomic and biological characteristics of the isolated phage X5 were evaluated. Phage X5 has a broad host range, high tolerance to extreme conditions, and strong antibacterial ability. The lysis rate of phage X5 was 87.50% (70/80), which was higher than that of phage GSP044, at 81.25% (39/48) [61]. For phage-insensitive Salmonella strains, it is speculated that the tail protein of phage X5 cannot recognize these bacteria. The specific recognition mechanism or the use of phage cocktails will be investigated in the future [62]. Additionally, phage X5 had an adequate scavenging effect on the mature bacterial biofilm and effectively reduced the bacterial load in the biofilm. Compared with plant essential oils, enzyme preparation, and lactic acid bacteria, although they have antibacterial effects, their antibacterial spectrum is relatively wide, which may affect or destroy the balance of normal flora. Phages have the advantages of strict host specificity, strong exponential proliferation ability as well as high safety and ecological friendliness in the field of anti–pathogenic biofilms, which gives phages broad application prospects in the field of antimicrobial therapy [63]. The bacterial load was significantly lower in the treatment groups (MOI of 100 and 1000) than in the control group at 24 h, indicating that phage X5 could significantly inhibit the host bacteria in the milk matrix, whether at 4 °C or 25 °C. These findings suggest that phage X5 is a promising and effective biological control agent for controlling Salmonella infection in the food industry. At present, we have studied the recognition receptor of phage X5, preliminarily analyzed the receptor site, and studied the phage resistance.
The application of phages in the food industry has considerable potential but also faces some challenges and comes with potential risks, such as consumer acceptance, security assessment, technical limitations, potential drug resistance, and effective use in food production. Therefore, there are no approved phage food bacteriostatic agents in China. However, the phage product of Qingdao Phagepharm Bio–Tech Co., Ltd. (Qingdao, China) has been approved by The U. S. Food and Drug Administration (FDA). Considered Generally Recognized as Safe (GRAS), this phage product is expected to play an important role in the international market (https://www.fda.gov/media/178868/download, accessed on 30 May 2024). Our future work will focus on the prevention of Salmonella infection by X5 lyase and on the identification of receptor–binding proteins. Phage X5 has the potential to be used in phage preparations for the prevention of Salmonella infection in the food, agriculture, medical, aquaculture, livestock, agroforestry, and environmental industries.
5. Conclusions
A virulent phage X5 that targets S. pullorum was isolated in this study. Phage X5 exhibits a broad host range, resistance to heat and pH variations, and a short latency period. The results revealed that phage X5 has potential application value as a biocontrol agent for removing biofilm formation of S. pullorum and as an alternative for the prevention and control of S. pullorum contamination of milk and chicken meat.
Author Contributions
X.J.: writing–original draft, visualization, data curation, software. X.S. and Q.L. (Qin Lu): investigation, resources, writing–review and editing. Z.W.; Z.Z. and X.L.: investigation and methodology. R.L. and Y.X.: resources. J.Y. and L.L.: formal analysis. T.Z. and Q.L. (Qingping Luo): project administration. G.C. and Q.L. (Qingping Luo): conceptualization, funding acquisition. All authors have read and agreed to the published version of the manuscript.
Funding
Rural revitalization science and technology of Jingchuxing program (2662024FW012), Huazhong Agricultural University. State Key Research and development program (2022YFD1800602), the China Agriculture Research System of MOF and MARA (CARS–41), the Key Projects of Hubei Natural Science Foundation (2021CFA019), and the Key Research and Development Project of Hubei Province 2022BBA0055. The authors would like to thank members of their laboratory for their helpful and constructive advice.
Data Availability Statement
The original contributions presented in the study are included in the article, further inquiries can be directed to the corresponding authors.
Conflicts of Interest
The authors declare no conflict of interest.
References
- World Health Organization. WHO Estimates of the Global Burden of Foodborne Diseases: Foodborne Disease Burden Epidemiology Reference Group 2007–2015; World Health Organization: Geneva, Switzerland, 2015. [Google Scholar]
- Scallan, E.; Hoekstra, R.M.; Angulo, F.J.; Tauxe, R.V.; Widdowson, M.A.; Roy, S.L.; Jones, J.L.; Griffin, P.M. Foodborne illness acquired in the United States--major pathogens. Emerg. Infect. Dis. 2011, 17, 7–15. [Google Scholar] [CrossRef] [PubMed]
- Cahill, J.; Young, R. Phage Lysis: Multiple Genes for Multiple Barriers. Adv. Virus Res. 2019, 103, 33–70. [Google Scholar] [CrossRef]
- Li, K.; Ye, S.; Alali, W.Q.; Wang, Y.; Wang, X.; Xia, X.; Yang, B. Antimicrobial susceptibility, virulence gene and pulsed-field gel electrophoresis profiles of Salmonella enterica serovar Typhimurium recovered from retail raw chickens, China. Food Control 2017, 72, 36–42. [Google Scholar] [CrossRef]
- Punchihewage-Don, A.J.; Hawkins, J.; Adnan, A.M.; Hashem, F.; Parveen, S. The outbreaks and prevalence of antimicrobial resistant Salmonella in poultry in the United States: An overview. Heliyon 2022, 8, e11571. [Google Scholar] [CrossRef] [PubMed]
- Yin, J.; Xiong, W.; Yuan, X.; Li, S.; Zhi, L.; Pan, P.; Sun, W.; Yu, T.; He, Q.; Cheng, Z. Salmonella Pullorum lacking srfA is attenuated, immunogenic and protective in chickens. Microb. Pathog. 2021, 161 Pt A, 105230. [Google Scholar] [CrossRef]
- Ao, T.T.; Feasey, N.A.; Gordon, M.A.; Keddy, K.H.; Angulo, F.J.; Crump, J.A. Global burden of invasive nontyphoidal Salmonella disease, 20101. Emerg. Infect. Dis. 2015, 21, 941–949. [Google Scholar] [CrossRef]
- Shivaprasad, H.L. Fowl typhoid and pullorum disease. Rev. Sci. Tech. 2000, 19, 405–424. [Google Scholar] [CrossRef]
- Duc, H.M.; Son, H.M.; Honjoh, K.-i.; Miyamoto, T. Isolation and application of bacteriophages to reduce Salmonella contamination in raw chicken meat. LWT-Food Sci. Technol. 2018, 91, 353–360. [Google Scholar] [CrossRef]
- Li, J.; Li, Y.; Ding, Y.; Huang, C.; Zhang, Y.; Wang, J.; Wang, X. Characterization of a novel Siphoviridae Salmonella bacteriophage T156 and its microencapsulation application in food matrix. Food Res. Int. 2021, 140, 110004. [Google Scholar] [CrossRef]
- Carvalho, C.; Costa, A.R.; Silva, F.; Oliveira, A. Bacteriophages and their derivatives for the treatment and control of food-producing animal infections. Crit. Rev. Microbiol. 2017, 43, 583–601. [Google Scholar] [CrossRef]
- Lasagabaster, A.; Jimenez, E.; Lehnherr, T.; Miranda-Cadena, K.; Lehnherr, H. Bacteriophage biocontrol to fight Listeria outbreaks in seafood. Food Chem. Toxicol. 2020, 145, 111682. [Google Scholar] [CrossRef] [PubMed]
- Newase, S.; Kapadnis, B.P.; Shashidhar, R. Isolation and Genome Sequence Characterization of Bacteriophage vB_SalM_PM10, a Cba120virus, Concurrently Infecting Salmonella enterica Serovars Typhimurium, Typhi, and Enteritidis. Curr. Microbiol. 2019, 76, 86–94. [Google Scholar] [CrossRef] [PubMed]
- Li, Y.; Lv, P.; Shi, D.; Zhao, H.; Yuan, X.; Jin, X.; Wang, X. A Cocktail of Three Virulent Phages Controls Multidrug-Resistant Salmonella Enteritidis Infection in Poultry. Front. Microbiol. 2022, 13, 940525. [Google Scholar] [CrossRef] [PubMed]
- Wang, S.; Mirmiran, S.D.; Li, X.; Li, X.; Zhang, F.; Duan, X.; Gao, D.; Chen, Y.; Chen, H.; Qian, P. Temperate phage influence virulence and biofilm-forming of Salmonella Typhimurium and enhance the ability to contaminate food product. Int. J. Food Microbiol. 2023, 398, 110223. [Google Scholar] [CrossRef]
- Islam, M.S.; Zhou, Y.; Liang, L.; Nime, I.; Yan, T.; Willias, S.P.; Mia, M.Z.; Bei, W.; Connerton, I.F.; Fischetti, V.A.; et al. Application of a Broad Range Lytic Phage LPST94 for Biological Control of Salmonella in Foods. Microorganisms 2020, 8, 247. [Google Scholar] [CrossRef]
- Guo, Y.; Li, J.; Islam, M.S.; Yan, T.; Zhou, Y.; Liang, L.; Connerton, I.F.; Deng, K.; Li, J. Application of a novel phage vB_SalS-LPSTLL for the biological control of Salmonella in foods. Food Res. Int. 2021, 147, 110492. [Google Scholar] [CrossRef]
- Lee, W.J.; Billington, C.; Hudson, J.A.; Heinemann, J.A. Isolation and characterization of phages infecting Bacillus cereus. Lett. Appl. Microbiol. 2011, 52, 456–464. [Google Scholar] [CrossRef]
- Aziz, R.K.; Ackermann, H.W.; Petty, N.K.; Kropinski, A.M. Essential Steps in Characterizing Bacteriophages: Biology, Taxonomy, and Genome Analysis. Methods Mol. Biol. 2018, 1681, 197–215. [Google Scholar] [CrossRef] [PubMed]
- Tie, K.; Yuan, Y.; Yan, S.; Yu, X.; Zhang, Q.; Xu, H.; Zhang, Y.; Gu, J.; Sun, C.; Lei, L.; et al. Isolation and identification of Salmonella pullorum bacteriophage YSP2 and its use as a therapy for chicken diarrhea. Virus Genes 2018, 54, 446–456. [Google Scholar] [CrossRef]
- Shang, Y.; Sun, Q.; Chen, H.; Wu, Q.; Chen, M.; Yang, S.; Du, M.; Zha, F.; Ye, Q.; Zhang, J. Isolation and Characterization of a Novel Salmonella Phage vB_SalP_TR2. Front. Microbiol. 2021, 12, 664810. [Google Scholar] [CrossRef]
- Sui, B.; Han, L.; Ren, H.; Liu, W.; Zhang, C. A Novel Polyvalent Bacteriophage vB_EcoM_swi3 Infects Pathogenic Escherichia coli and Salmonella enteritidis. Front. Microbiol. 2021, 12, 649673. [Google Scholar] [CrossRef]
- Lopez-Cuevas, O.; Castro-Del Campo, N.; Leon-Felix, J.; Gonzalez-Robles, A.; Chaidez, C. Characterization of bacteriophages with a lytic effect on various Salmonella serotypes and Escherichia coli O157:H7. Can. J. Microbiol. 2011, 57, 1042–1051. [Google Scholar] [CrossRef] [PubMed]
- Oduor, J.M.O.; Kadija, E.; Nyachieo, A.; Mureithi, M.W.; Skurnik, M. Bioprospecting Staphylococcus Phages with Therapeutic and Bio-Control Potential. Viruses 2020, 12, 133. [Google Scholar] [CrossRef] [PubMed]
- Huang, C.; Virk, S.M.; Shi, J.; Zhou, Y.; Willias, S.P.; Morsy, M.K.; Abdelnabby, H.E.; Liu, J.; Wang, X.; Li, J. Isolation, Characterization, and Application of Bacteriophage LPSE1 Against Salmonella enterica in Ready to Eat (RTE) Foods. Front. Microbiol. 2018, 9, 1046. [Google Scholar] [CrossRef]
- Sun, W.J.; Liu, C.F.; Yu, L.; Cui, F.J.; Zhou, Q.; Yu, S.L.; Sun, L. A novel bacteriophage KSL-1 of 2-Keto-gluconic acid producer Pseudomonas fluorescens K1005: Isolation, characterization and its remedial action. BMC Microbiol. 2012, 12, 127. [Google Scholar] [CrossRef] [PubMed]
- Manohar, P.; Tamhankar, A.J.; Lundborg, C.S.; Nachimuthu, R. Therapeutic Characterization and Efficacy of Bacteriophage Cocktails Infecting Escherichia coli, Klebsiella pneumoniae, and Enterobacter Species. Front. Microbiol. 2019, 10, 574. [Google Scholar] [CrossRef]
- Hooton, S.P.; Atterbury, R.J.; Connerton, I.F. Application of a bacteriophage cocktail to reduce Salmonella Typhimurium U288 contamination on pig skin. Int. J. Food Microbiol. 2011, 151, 157–163. [Google Scholar] [CrossRef]
- Duc, H.M.; Son, H.M.; Yi, H.P.S.; Sato, J.; Ngan, P.H.; Masuda, Y.; Honjoh, K.I.; Miyamoto, T. Isolation, characterization and application of a polyvalent phage capable of controlling Salmonella and Escherichia coli O157:H7 in different food matrices. Food Res. Int. 2020, 131, 108977. [Google Scholar] [CrossRef]
- Yuan, Y.; Zhao, F.; Wang, L.; Tan, D.; Cong, C.; Li, X.; Xu, Y. Complete genome analysis of the novel Enterococcus faecalis phage vB_EfaS_AL3. Arch. Virol. 2019, 164, 2599–2603. [Google Scholar] [CrossRef]
- Bankevich, A.; Nurk, S.; Antipov, D.; Gurevich, A.A.; Dvorkin, M.; Kulikov, A.S.; Lesin, V.M.; Nikolenko, S.I.; Pham, S.; Prjibelski, A.D.; et al. SPAdes: A new genome assembly algorithm and its applications to single-cell sequencing. J. Comput. Biol. 2012, 19, 455–477. [Google Scholar] [CrossRef]
- Grant, J.R.; Stothard, P. The CGView Server: A comparative genomics tool for circular genomes. Nucleic Acids Res. 2008, 36, W181–W184. [Google Scholar] [CrossRef] [PubMed]
- Mount, D.W. Using the Basic Local Alignment Search Tool (BLAST). CSH Protoc. 2007, 2007, pdb-top17. [Google Scholar] [CrossRef] [PubMed]
- Mitchell, A.L.; Attwood, T.K.; Babbitt, P.C.; Blum, M.; Bork, P.; Bridge, A.; Brown, S.D.; Chang, H.Y.; El-Gebali, S.; Fraser, M.I.; et al. InterPro in 2019: Improving coverage, classification and access to protein sequence annotations. Nucleic Acids Res. 2019, 47, D351–D360. [Google Scholar] [CrossRef] [PubMed]
- Kumar, S.; Stecher, G.; Li, M.; Knyaz, C.; Tamura, K. MEGA X: Molecular Evolutionary Genetics Analysis across Computing Platforms. Mol. Biol. Evol. 2018, 35, 1547–1549. [Google Scholar] [CrossRef] [PubMed]
- Sullivan, M.J.; Petty, N.K.; Beatson, S.A. Easyfig: A genome comparison visualizer. Bioinformatics 2011, 27, 1009–1010. [Google Scholar] [CrossRef]
- Kostaki, M.; Chorianopoulos, N.; Braxou, E.; Nychas, G.J.; Giaouris, E. Differential biofilm formation and chemical disinfection resistance of sessile cells of Listeria monocytogenes strains under monospecies and dual-species (with Salmonella enterica) conditions. Appl. Environ. Microbiol. 2012, 78, 2586–2595. [Google Scholar] [CrossRef]
- de Ornellas Dutka Garcia, K.C.; de Oliveira Correa, I.M.; Pereira, L.Q.; Silva, T.M.; de Souza Ribeiro Mioni, M.; de Moraes Izidoro, A.C.; Vellano Bastos, I.H.; Marietto Goncalves, G.A.; Okamoto, A.S.; Andreatti Filho, R.L. Bacteriophage use to control Salmonella biofilm on surfaces present in chicken slaughterhouses. Poult. Sci. 2017, 96, 3392–3398. [Google Scholar] [CrossRef]
- Shan, W.; Zhang, H.; Kan, J.; Yin, M.; Zhang, J.; Wan, L.; Chang, R.; Li, M. Acquired mucoid phenotype of Acinetobacter baumannii: Impact for the molecular characteristics and virulence. Microbiol. Res. 2021, 246, 126702. [Google Scholar] [CrossRef]
- Hong, Y.; Schmidt, K.; Marks, D.; Hatter, S.; Marshall, A.; Albino, L.; Ebner, P. Treatment of Salmonella-Contaminated Eggs and Pork with a Broad-Spectrum, Single Bacteriophage: Assessment of Efficacy and Resistance Development. Foodborne Pathog. Dis. 2016, 13, 679–688. [Google Scholar] [CrossRef]
- Huang, C.; Shi, J.; Ma, W.; Li, Z.; Wang, J.; Li, J.; Wang, X. Isolation, characterization, and application of a novel specific Salmonella bacteriophage in different food matrices. Food Res. Int. 2018, 111, 631–641. [Google Scholar] [CrossRef]
- Hatfull, G.F.; Dedrick, R.M.; Schooley, R.T. Phage Therapy for Antibiotic-Resistant Bacterial Infections. Annu. Rev. Med. 2022, 73, 197–211. [Google Scholar] [CrossRef] [PubMed]
- Tadesse, G.; Gebremedhin, E.Z. Prevalence of Salmonella in raw animal products in Ethiopia: A meta-analysis. BMC Res. Notes 2015, 8, 163. [Google Scholar] [CrossRef] [PubMed]
- Li, Q.; Zhu, Y.; Yin, K.; Xu, L.; Yin, C.; Li, Y.; Ren, J.; Yuan, Y.; Jiao, X. Purification of recombinant IpaJ to develop an indirect ELISA-based method for detecting Salmonella enterica serovar Pullorum infections in chickens. BMC Vet. Res. 2019, 15, 3. [Google Scholar] [CrossRef] [PubMed]
- Cui, K.; Li, P.; Huang, J.; Lin, F.; Li, R.; Cao, D.; Hao, G.; Sun, S. Salmonella Phage CKT1 Effectively Controls the Vertical Transmission of Salmonella Pullorum in Adult Broiler Breeders. Biology 2023, 12, 312. [Google Scholar] [CrossRef]
- Huang, J.; Liang, L.; Cui, K.; Li, P.; Hao, G.; Sun, S. Salmonella phage CKT1 significantly relieves the body weight loss of chicks by normalizing the abnormal intestinal microbiome caused by hypervirulent Salmonella Pullorum. Poult. Sci. 2022, 101, 101668. [Google Scholar] [CrossRef]
- Leverentz, B.; Conway, W.S.; Alavidze, Z.; Janisiewicz, W.J.; Fuchs, Y.; Camp, M.J.; Chighladze, E.; Sulakvelidze, A. Examination of bacteriophage as a biocontrol method for Salmonella on fresh-cut fruit: A model study. J. Food Prot. 2001, 64, 1116–1121. [Google Scholar] [CrossRef]
- Bielke, L.; Higgins, S.; Donoghue, A.; Donoghue, D.; Hargis, B.M. Salmonella host range of bacteriophages that infect multiple genera. Poult. Sci. 2007, 86, 2536–2540. [Google Scholar] [CrossRef]
- Choi, I.Y.; Lee, J.H.; Kim, H.J.; Park, M.K. Isolation and Characterization of a Novel Broad-host-range Bacteriophage Infecting Salmonella enterica subsp. enterica for Biocontrol and Rapid Detection. J. Microbiol. Biotechnol. 2017, 27, 2151–2155. [Google Scholar] [CrossRef]
- Liu, R.; Han, G.; Li, Z.; Cun, S.; Hao, B.; Zhang, J.; Liu, X. Bacteriophage therapy in aquaculture: Current status and future challenges. Folia Microbiol. 2022, 67, 573–590. [Google Scholar] [CrossRef]
- El-Dougdoug, N.K.; Cucic, S.; Abdelhamid, A.G.; Brovko, L.; Kropinski, A.M.; Griffiths, M.W.; Anany, H. Control of Salmonella Newport on cherry tomato using a cocktail of lytic bacteriophages. Int. J. Food Microbiol. 2019, 293, 60–71. [Google Scholar] [CrossRef]
- Lal, T.M.; Sano, M.; Ransangan, J. Isolation and Characterization of Large Marine Bacteriophage (Myoviridae), VhKM4 Infecting Vibrio harveyi. J. Aquat. Anim. Health 2017, 29, 26–30. [Google Scholar] [CrossRef] [PubMed]
- Cao, S.; Yang, W.; Zhu, X.; Liu, C.; Lu, J.; Si, Z.; Pei, L.; Zhang, L.; Hu, W.; Li, Y.; et al. Isolation and identification of the broad-spectrum high-efficiency phage vB_SalP_LDW16 and its therapeutic application in chickens. BMC Vet. Res. 2022, 18, 386. [Google Scholar] [CrossRef]
- Lu, Y.; Shi, H.; Zhang, Z.; Han, F.; Li, J.; Sun, Y. Isolation and characterization of a lytic bacteriophage phiKp-lyy15 of Klebsiella pneumoniae. Virol. Sin. 2015, 30, 66–68. [Google Scholar] [CrossRef]
- Lewis, R.; Hill, C. Overcoming barriers to phage application in food and feed. Curr. Opin. Biotechnol. 2020, 61, 38–44. [Google Scholar] [CrossRef]
- Li, X.; Zhang, C.; Wei, F.; Yu, F.; Zhao, Z. Bactericidal activity of a holin-endolysin system derived from Vibrio alginolyticus phage HH109. Microb. Pathog. 2021, 159, 105135. [Google Scholar] [CrossRef] [PubMed]
- Wang, I.N.; Smith, D.L.; Young, R. Holins: The protein clocks of bacteriophage infections. Annu. Rev. Microbiol. 2000, 54, 799–825. [Google Scholar] [CrossRef]
- Washizaki, A.; Yonesaki, T.; Otsuka, Y. Characterization of the interactions between Escherichia coli receptors, LPS and OmpC, and bacteriophage T4 long tail fibers. Microbiologyopen 2016, 5, 1003–1015. [Google Scholar] [CrossRef]
- Steinbacher, S.; Baxa, U.; Miller, S.; Weintraub, A.; Seckler, R.; Huber, R. Crystal structure of phage P22 tailspike protein complexed with Salmonella sp. O-antigen receptors. Proc. Natl. Acad. Sci. USA 1996, 93, 10584–10588. [Google Scholar] [CrossRef] [PubMed]
- Rehman, S.; Ali, Z.; Khan, M.; Bostan, N.; Naseem, S. The dawn of phage therapy. Rev. Med. Virol. 2019, 29, e2041. [Google Scholar] [CrossRef]
- Gao, D.; Ji, H.; Li, X.; Ke, X.; Li, X.; Chen, P.; Qian, P. Host receptor identification of a polyvalent lytic phage GSP044, and preliminary assessment of its efficacy in the clearance of Salmonella. Microbiol. Res. 2023, 273, 127412. [Google Scholar] [CrossRef]
- Song, Y.; Gu, W.; Hu, Y.; Zhang, B.; Wang, J.; Sun, Y.; Fu, W.; Li, X.; Xing, X.; Wang, S. Isolation and Characterization of Two Novel Lytic Bacteriophages against Salmonella typhimurium and Their Biocontrol Potential in Food Products. Foods 2024, 13, 3103. [Google Scholar] [CrossRef] [PubMed]
- Pang, X.; Hu, X.; Du, X.; Lv, C.; Yuk, H.G. Biofilm formation in food processing plants and novel control strategies to combat resistant biofilms: The case of Salmonella spp. Food Sci. Biotechnol. 2023, 32, 1703–1718. [Google Scholar] [CrossRef] [PubMed]
Disclaimer/Publisher’s Note: The statements, opinions and data contained in all publications are solely those of the individual author(s) and contributor(s) and not of MDPI and/or the editor(s). MDPI and/or the editor(s) disclaim responsibility for any injury to people or property resulting from any ideas, methods, instructions or products referred to in the content. |
© 2024 by the authors. Licensee MDPI, Basel, Switzerland. This article is an open access article distributed under the terms and conditions of the Creative Commons Attribution (CC BY) license (https://creativecommons.org/licenses/by/4.0/).